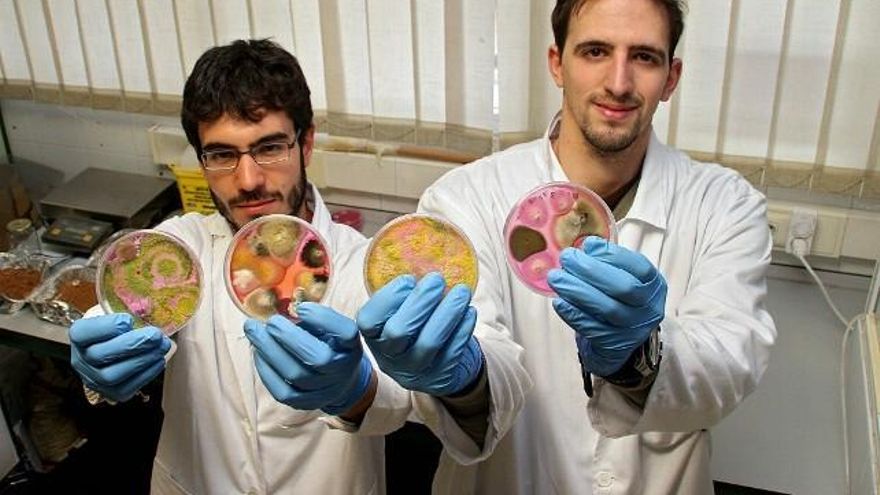
Peio García / ICAL Dos miembros del equipo con placas de Petri cultivadas

La ULE desarrolla un método de control biológico de lucha entre hongos para frenar una enfermedad de la vid

Un equipo de la Escuela Superior y Técnica de Ingeniería Agraria (Estia) de la Universidad de León (ULE) desarrolla un método de control biológico de lucha entre hongos para frenar la yesca, una enfermedad que afecta a la madera de la vid en 1.600 hectáreas de viñedo de Castilla y León. La solución está en la Trichoderma, un hongo que se encuentra en la propia planta y del que se ha descubierto que, pasado el tiempo, acelera la recuperación de la viña de forma natural. Se trata de una cuestión novedosa y que sólo otro grupo afincado en Austria ha logrado conclusiones similares.
“Es capaz de abatir el hongo 'malo', en un ambiente determinado”, destaca en declaraciones a Ical el coordinador del proyecto, el doctor, ingeniero agrónomo y catedrático de la Estia, Pedro Antonio Casquero, quien asegura que se podrían tener “resultados claros” para su utilización de forma genérica en un lustro, siempre que el grupo reciba el apoyo y financiación necesarios. “Si nos apoyan y tenemos financiación, estas investigaciones llegarán lejos. Se trata de la importancia de mantener las cepas sanas para fijar población en el medio rural”, alaba.
Esta investigación, que recientemente ha sido reconocida por el Consejo Económico y Social y las tres universidades públicas de la Comunidad, se ha centrado en aquellos entornos en los que la yesca es más activa y en determinadas variedades. Esto significa que ha dado resultados positivos en las denominaciones de origen en las que este equipo se ha centrado: Bierzo, Toro, Ribera y León, con las variedades tradicionales de Tempranillo, Prieto Picudo y Mencía.
El trabajo aborda el problema que presentan los viñedos de Castilla y León debido a los hongos que atacan la madera de vid. “La yesca son un montón de hongos y afecta al dos por ciento de los viñedos de la Comunidad”, advierte Casquero, quien llega incluso a considerarla como la 'filoxera' del siglo XXI. Hasta ahora no se conocía una solución eficaz, “pero la Trichoderma lo es”. “Está presente en la rizosfera de las plantas. Es oportunista, un simbionte no virulento y parásito y antagonista de muchos hongos fitopatógenos, con lo que podría proteger a la planta de distintas enfermedades. Coloniza la raíz (rizosfera) y se establece rápidamente en la comunidad microbiológica que hay en ella”, explica técnicamente. Traducido al argot de la calle, significa que este hongo controla al patógeno y “compite o reduce la microflora empleando distintos mecanismos”.
Los investigadores, que aseguran que el uso de este hongo en la agricultura tiene numerosas ventajas, observaron que las plantas de vid afectadas por yesca pasaban por varias fases de afectación graves. Algunas, las que menos tratamientos fitosanitarios tenían, eran capaces de recuperarse pasado el tiempo. “Entendemos que había alguna lucha biológica con algún agente. Entonces los aislamos y vimos que eran del género Trichoderma”.
Todo se explica, resume Casquero, en que al enfrentar al hongo “malo y al bueno, siempre gana el bueno”, un experimento también comprobado in vitro en estaquillas, en semicampo, donde también ha funcionado “porque el hongo es capaz de moverse por la planta”, algo demostrado por primera vez. “El hongo bueno lo hemos extraído de cepas antiguas y nuevas, pero son las antiguas las que más cantidad albergan porque llevan más tiempo luchando contra los patógenos y se ha producido una selección natural”, confirma el coordinador del equipo, quien indicaa que Trichoderma es “competitivo, pero si se dan muchos tratamientos con pesticidas, morirán los malos y los buenos”.
No habrá solución única
Una de las características de la investigación, remarca el catedrático, es que existe una “especificidad bastante alta” entre el hongo patógeno que ataca y la especie Trichoderma que será capaz de controlarlo en un ambiente “determinado” que se refiere al entorno, que en una Comunidad tan amplia como Castilla y León difiere mucho entre territorios, porque el clima, humedad o superficie no es la misma en Bierzo, Ribera del Duero o Toro, entre otros. “No existirá una solución única para todos los ambientes. No es la panacea para todo el mundo”, insiste Casquero.
No obstante, recalca que el objetivo es que este hongo se pudiera comercializar en un futuro, en cuatro o cinco años, en las zonas “en las que se ha trabajado”, pero el equipo reconoce que aún “no está en esa fase”.
Sin embargo, admite que son varias las bodegas que ya se han interesado por esta investigación que podría poner limitaciones a la yesca. En la actualidad, las comarcas vitícolas más afectadas son Toro, Ribera del Duero, Cigales y Tierra del Vino de Zamora, cuya afección supera al dos por ciento de la superficie, incluso las dos primeras por encima del tres por ciento.

Existe otra categorías de áreas “medianamente afectadas”: Arlanza, Arribes del Duero, Bierzo, Rueda y Valles de Benavente, con un grado de afección “más bajo, aunque preocupante”, y una tercera con “daño menor”, entre las que se encuentran las DO León, Valtiendas y Sierra de Salamanca, con una incidencia inferior al uno por ciento. Con los tres diferentes grados, prosigue Casquero, se puede encontrar un agroecosistema con distinto nivel “de presión” y se puede comprobar si la Trichoderma de unas u otras zonas son más eficaces en función del estrés al que estén sometidos.
Por todo ello, los autores del estudio llaman a preservar las cepas viejas de Castilla y León. Hace más de 20 años se contabilizaban en Ribera del Duero unas 6.000 hectáreas de viñedo viejo y ahora sólo quedan 2.000. Este estudio pone de relevancia la “importancia de los viñedos con el fin de concienciar a la sociedad y administraciones para tomar medidas que eviten la muerte de cepas por causa de las enfermedades de la madera de la vid”.
En la actualidad, existen otras plagas, como la Xylotrechus arvícola, con gran afección a viñedos de Toro y Ribera de Duero. Este insecto es capaz de favorecer la entrada de las enfermedades y por tanto es importante reducir su población. Para ello, el catedrático propone también el estudio de una “interacción conjunta entre enfermedades y plagas de la madera de vid en relación al uso de Trichoderma como agente de biocontrol”.



